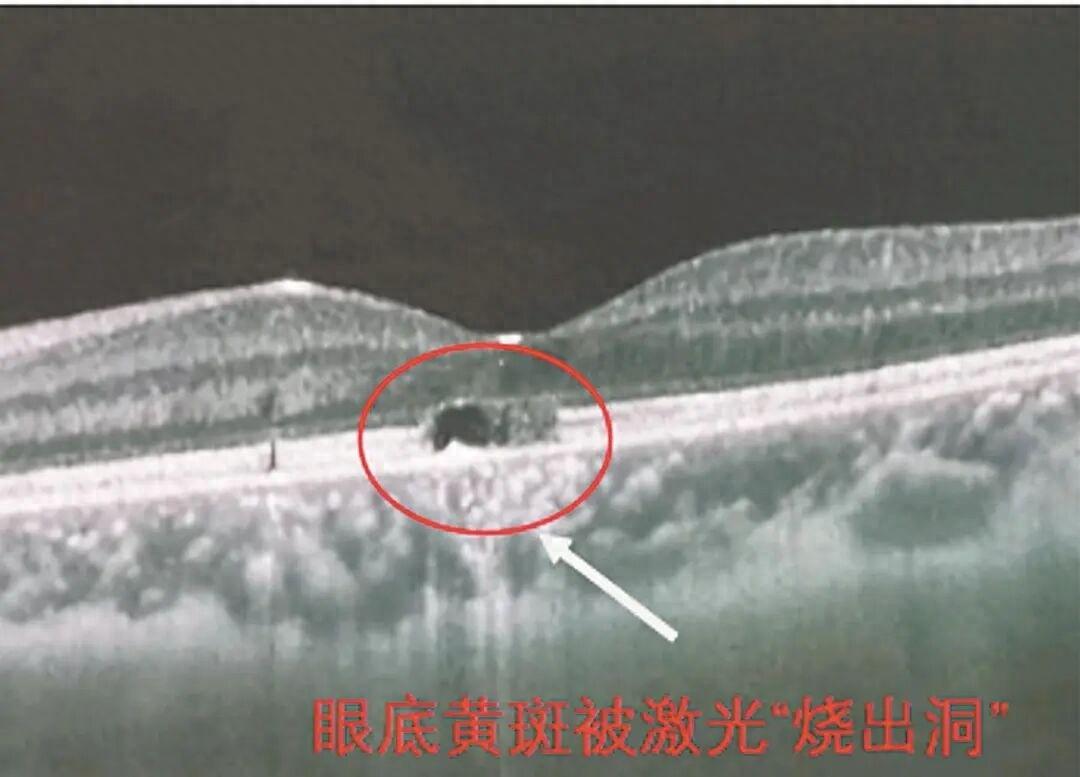
“悲剧还是发生了！”福建，8岁男孩和同学玩耍时，不小心被同学用激光笔照了一下眼睛

标签: 激光笔
别让“激光笔”成了“伤眼器”
“激光笔”作为常见的教学辅助工具和演示设备,被广泛应用于科研、教育及商业展示等场景。由于“激光笔”发射的激光束具有高能量密度特性,如果使用不当,可能对人的眼睛和皮肤造成严重伤害。同时,因对其危险性不甚了解,不少...
塞内加尔航空寻找昔日激光笔扫射萨拉赫的球迷,资助他观战非洲杯
塞内加尔航空在网上公开寻找用激光笔照射萨拉内的“幸运”球迷,全额资助其到摩洛哥现场观战非洲杯。塞内加尔航空(FlyAirSénégal)创立于2016年,是塞内加尔国有航空企业。塞内加尔航空官推发布信息: 帮我们找到他!在上次...
抽象!塞内加尔航空邀请此前激光笔干扰萨拉赫的球迷观赛
他的脸上和身上被大量绿色激光笔光束照射(看台球迷从多个方向射来,画面显示他几乎“变绿”),干扰非常明显。最终萨拉赫罚丢,将球直接踢飞过横梁,埃及也是点球大战不敌塞内加尔无缘世界杯。塞内加尔媒体报道全文: 随着...
经典非洲杯激光笔!马里队前场任意球,主罚球员面部被激光笔狂照
直播吧01月10日讯非洲杯1/4决赛,塞内加尔1-0马里成功晋级。比赛第84分钟,马里队获得前场定位球,主罚的球员开出任意球前面部被观众用激光笔疯狂干扰,而这个任意球刚刚开进塞内加尔禁区就被解围了出来。
日本战机再遭激光袭击!防卫大臣急甩锅中国,舆论场惊现魔幻操作
⚖️ 民用激光笔属合法商品(亚马逊日本月销超2万支) 【国际观察:东亚安全困局新切口】 兰德智库分析师: 本次事件暴露日本三大战略焦虑: 1️⃣ 对中国军事技术进步的过度恐慌(误判激光武器实战化进程) 2️⃣ 自卫队应对...